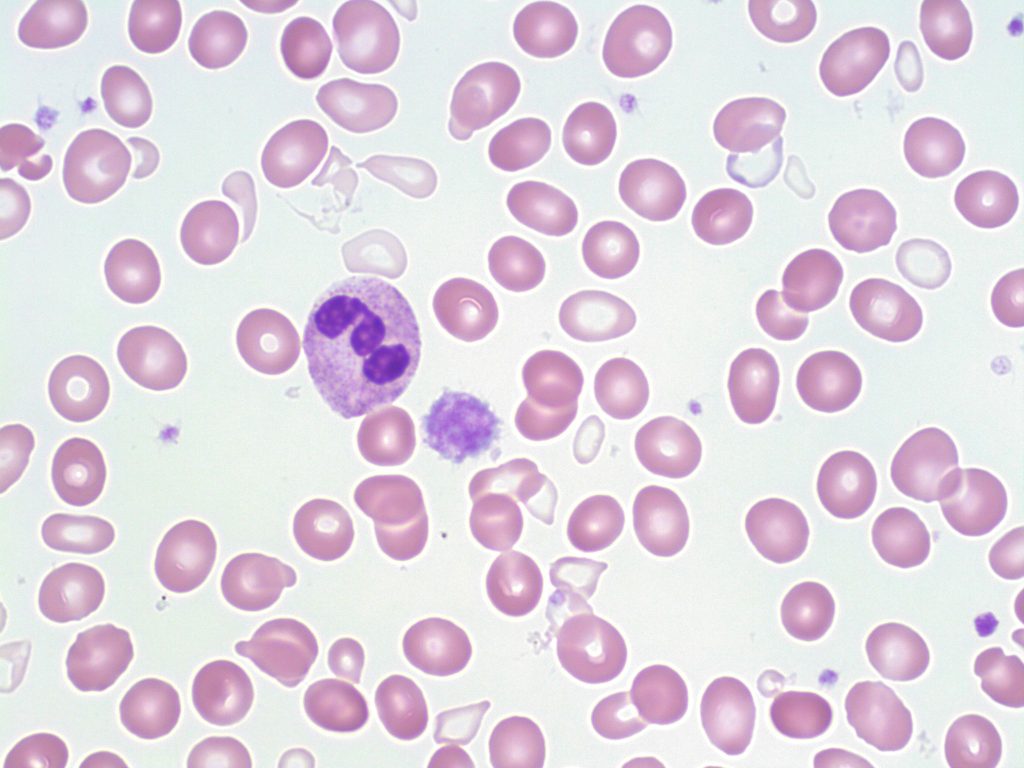

Υποχρωμία. Η υποχρωμία είναι διαταραχή της μορφολογίας των ερυθρών και είναι η ελάττωση της έντασης του χρώματος των ερυθρών αιμοσφαιρίων
Υποχρωμία
Η παρατήρηση των μορφολογικών διαταραχών των ερυθρών αιμοσφαιρίων γίνεται με το μικροσκόπιο, σε επίχρισμα περιφερικού αίματος, μετά από άμεση επίστρωση σε πλακάκι.
Η άμεση επίστρωση είναι απαραίτητη, γιατί διαταράσσεται η μορφολογία των ερυθρών όταν το αίμα μπει σε αντιπηκτικό.
Επίσης, θα πρέπει η περιοχή λήψης αίματος να στεγνώσει από το οινόπνευμα, γιατί το οινόπνευμα συρρικνώνει τα ερυθρά αιμοσφαίρια.
Τεχνική λήψης επιχρίσματος περιφερικού αίματος
-Μετά την λήψη αίματος απορρίπτονται οι πρώτες σταγόνες από την βελόνα.
-Στη συνέχεια μπαίνει λεπτή επίστρωση στο πλακάκι.
-Η επίστρωση αφήνεται να ξεραθεί.
-Γίνεται χρώση με May-Grunwald-Giemsa.
-Γίνεται παρατήρηση στο μικροσκόπιο ενός αντιπροσωπευτικού πεδίου από το επίχρισμα στο πλακάκι.

Τι είναι η υποχρωμία
Υποχρωμία είναι η ελάττωση της έντασης του χρώματος των ερυθρών αιμοσφαιρίων, αύξηση της κεντρικής ωχρής περιοχής (φυσιολογικά είναι το 1/3 της διαμέτρου του ερυθρού) και μείωση της πυκνότητας της αιμοσφαιρίνης κατά ερυθρό αιμοσφαίριο (MCHC/Mean Corpuscular Hemoglobin Concentration μικρότερη από 30 g/dl, MCH/mean corpuscular hemoglobin/μέση αιμοσφαιρίνη των κυττάρων μικρότερη από 27 pg).
Παρατηρείται στη σιδηροπενική αναιμία, στη σιδηροβλαστική αναιμία, στη μεσογειακή αναιμία, στις αιμοσφαιρινοπάθειες (C και Ε), στη μολυβδίαση, στην ανεπάρκεια της τρανσφερίνης, στην αναιμία χρόνιων νοσημάτων (π.χ. νοσήματα κολλαγόνου, κακοήθη νοσήματα κ.λπ.).
emedi diagnostic tests
Υψηλής Ποιότητας Συμπλήρωμα Διατροφής για την Υγεία του Αίματος
Πατήστε, εδώ, για να παραγγείλετε το Υψηλής Ποιότητας Συμπλήρωμα Διατροφής για την Υγεία του Αίματος

Τα κατάλληλα συμπληρώματα Διατροφής για την Υγεία σας
Πατήστε, εδώ, για να παραγγείλετε τα κατάλληλα συμπληρώματα διατροφής για την υγεία σας
Διαβάστε, επίσης,
Μακροκυττάρωση στο πλακάκι αίματος
Ποικιλοκυττάρωση σε πλακάκι αίματος




